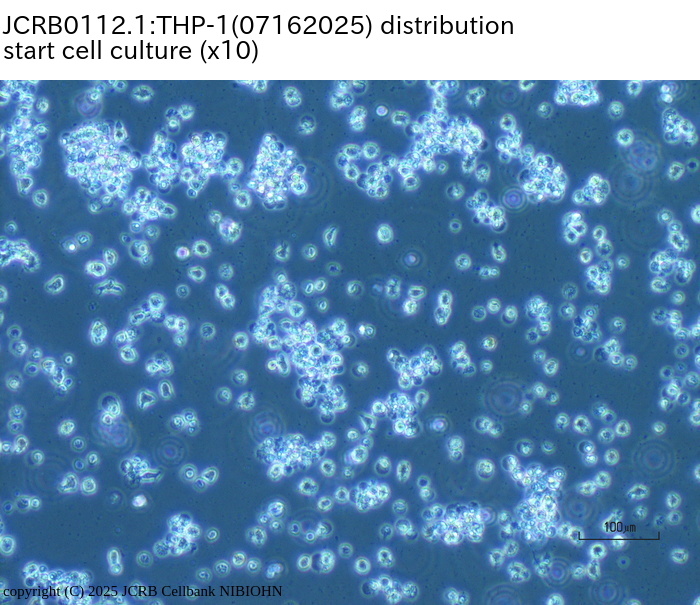
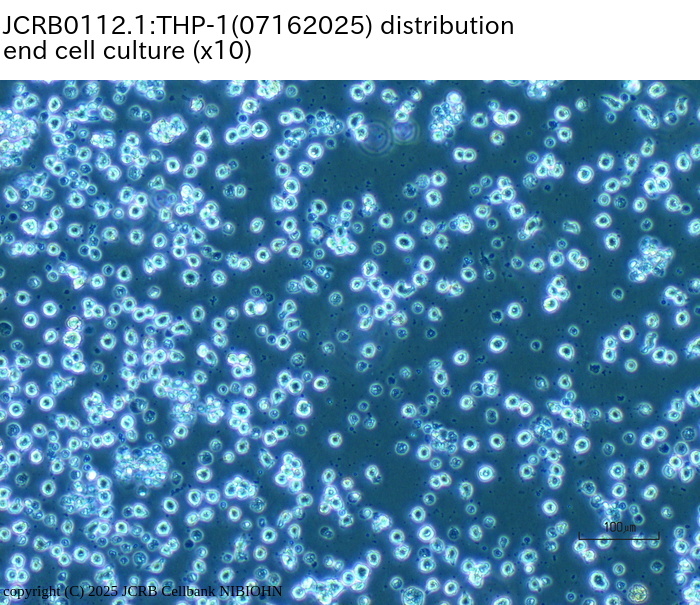

JCRB0112.1 THP-1
Cell information
Important Notice(s)THP-1細胞の登録番号JCRB0112, JCRB0112.1の違い / Difference in JCRB0112 and JCRB0112.1
THP-1 (JCRB0112.1): When you start culture/培養開始時のお願い
Cell type:general cells (View Pricing Information)
| JCRB No. | JCRB0112.1 | Cell Name | THP-1 |
|---|---|---|---|
| Profile | Human acute monocytic leukemia. | Other Name | THP-1/ATCC |
| Animal | human | Strain | |
| Genus | Homo | Species | sapiens |
| Sex | M | Age | young |
| Identity | available | Tissue for Primary Cancer | hemo-lymphocytic |
| Case history | acute monocytic leukemia | Metastasis | No |
| Tissue Metastasized | Genetics | Fc,C3b receptor.HLA-A2,-A9,-B5,-DRW1,-DRW2 (original description for THP-1 by developer in 1980). | |
| Life Span | infinite | Crisis PDL | |
| Morphology | lymphocyte-like | Character | No immuno globulin productions. |
| Classify | tumor | Established by | Tsuchiya,S. |
| Registered by | Tsuchiya,S. | Regulation for Distribution | Regulation not applied. |
| Comment | HLA-DR, My7, My9, OKM1 positive. Nonspecific peroxidase positive, peroxidase negative, a-naftol ASD chloroacetate esterase negative. by Dr. Tsuchiya. | Year | 1987 |
| Medium | RPMI1640 medium with 5% fetal calf serum. | Methods for Passages | Dilution, twice a week. |
| Cell Number on Passage | 2-5x10^5 cells/ml | Race | Japanese |
| CO2 Conc. | 5 % | Tissue Sampling | peripheral blood |
| Tissue Type |
| Detection of virus genome fragment by Real-time PCR | |||||||||
|---|---|---|---|---|---|---|---|---|---|
| Detected DNA Virus | tested | Detected RNA Virus | tested | ||||||
| CMV | - | parvoB19 | - | HCV | - | HTLV-1 | - | ||
| EBV | - | HBV | - | HIV-1 | - | HTLV-2 | - | ||
| HHV6 | - | HTLV-1 | - | HIV-2 | - | HAV | - | ||
| HHV7 | - | HTLV-2 | - |
-/negative. +/positive. nt/not tested. (positive (+) does not immediately mean the production of infectious viral particles.) |
|||||
| BKV | - | HIV-1 | - | ||||||
| JCV | - | HIV-2 | - | ||||||
| ADV | - | HPV18 | - | ||||||
| Notes | |||||||||
| Reference | |
|---|---|
| Pubmed id:35373342 | THP-1 reference data: proposal of an in vitro branched evolution model for cancer cell lines. Kasai F,Hirayama N,Fukushima M,Kohara A,Nakamura Y Int J Cancer. 2022 Apr 3;(): |
| Pubmed id:2964957 | Regulation of Fc epsilon receptor expression on a human monoblast cell line U937. Mayumi M,Kawabe T,Kim KM,Heike T,Katamura K,Yodoi J,Mikawa H Clin Exp Immunol. 1988 Jan;71(1):202-6 |
| Pubmed id:3100613 | Lymphotoxin: induction of terminal differentiation of the human myeloid leukemia cell lines HL-60 and THP-1. Hemmi H,Nakamura T,Tamura K,Shimizu Y,Kato S,Miki T,Takahashi N,Muramatsu M,Numao N,Sugamura K J Immunol. 1987 Feb 1;138(3):664-6 |
| Pubmed id:2989063 | Induction of functional differentiation of a human monocytic leukemia cell line (THP-1) by retinoic acid and cholera toxin. Hemmi H,Breitman TR Jpn J Cancer Res. 1985 May;76(5):345-51 |
| Pubmed id:3855620 | Cells of a human monocytic leukemia cell line (THP-1) synthesize and secrete apolipoprotein E and lipoprotein lipase. Tajima S,Hayashi R,Tsuchiya S,Miyake Y,Yamamoto A Biochem Biophys Res Commun. 1985 Jan 16;126(1):526-31 |
| Pubmed id:6091813 | Lineage infidelity of a human myelogenous leukemia cell line. Palumbo A,Minowada J,Erikson J,Croce CM,Rovera G Blood. 1984 Nov;64(5):1059-63 |
| Pubmed id:6949641 | Induction of maturation in cultured human monocytic leukemia cells by a phorbol diester. Tsuchiya S,Kobayashi Y,Goto Y,Okumura H,Nakae S,Konno T,Tada K Cancer Res. 1982 Apr;42(4):1530-6 |
| Pubmed id:6970727 | Establishment and characterization of a human acute monocytic leukemia cell line (THP-1). Tsuchiya S,Yamabe M,Yamaguchi Y,Kobayashi Y,Konno T,Tada K Int J Cancer. 1980 Aug;26(2):171-6 |
| Images |
|---|
             |
LOT Information
Viability/Growth rate/Cell number are represented as actual values measured at lot presentation in JCRB, but are not guaranteed values. Additionally, the doubling time is a rough value measured during passages.- 06272012
- 09032010
- 11212005
- 072396
- 012492
- 112488
- 09222014
- 050297
- F00952
- 10282015
- 11012017
- 11102017
- 11092017
- 05242021
- 07262023
- 02132024
- 11012024
- 11112024
- 07162025
| Cell No. | JCRB0112.1 | Cell Name | |
|---|---|---|---|
| LOT No. | 06272012 | Lot Specification | distribution |
| Medium | RPMI 1640 medium with 5% fetal bovine serum (FBS; GIBCO Cat. # 10099). Use 10% FBS until cells grow stably. | Temperature | 37 C |
| Cell Density at Seeding | 1.5 - 4.0 x 10^5 cells/mL | Methods for Passages | Simple dilution (suspension culture) |
| Doubling Time | approx. 42 hrs | Cell Number in Vial (cells/1ml) | 2.3 x 10^6 |
| Viability at cell freezing (%) | 95.2 | Antibiotics Used | free |
| Passage Number | Unknown (8 at bank) | PDL | |
| Sterility: MYCOPLASMA | - | Sterility: BACTERIA | - |
| Sterility: FUNGI | - | Isozyme Analysis | Confirmed as human by NP, G6PD (type B), MD. |
| Chromosome Mode | Chromosome Information | ||
| Surface Antigen | DNA Profile (STR) | ||
| Adhesion | No | Exoteric Gene | |
| Medium for Freezing | 10% DMSO, 20% FBS - RPMI 1640 | CO2 Conc. | 5% |
| Viability immediately after thawing (%) | Additional information |
| Cell No. | JCRB0112.1 | Cell Name | THP-1 |
|---|---|---|---|
| LOT No. | 09032010 | Lot Specification | distribution |
| Medium | RPMI1640 medium(GIBCO) with 5% heat inactivated fetal bovine serum(SIGMA027K03911) | Temperature | 37 C |
| Cell Density at Seeding | 0.5-1x10^5 cells/ml | Methods for Passages | dilution,twice a week |
| Doubling Time | NT | Cell Number in Vial (cells/1ml) | 2.92x10^6 |
| Viability at cell freezing (%) | 99.1 | Antibiotics Used | free |
| Passage Number | p6* | PDL | NT |
| Sterility: MYCOPLASMA | - | Sterility: BACTERIA | - |
| Sterility: FUNGI | - | Isozyme Analysis | NT |
| Chromosome Mode | NT | Chromosome Information | NT |
| Surface Antigen | NT | DNA Profile (STR) | D5S818:11,12 D13S317:13 D7S820:10 D16S539:11,12 VWA:16 TH01:8,9.3 AM:X,Y TPOX:8,11 CSF1PO:11,13 |
| Adhesion | No | Exoteric Gene | NT |
| Medium for Freezing | Cell Banker BLC-1(Nihon Zenyaku Industries) | CO2 Conc. | 5 % |
| Viability immediately after thawing (%) | Additional information |
| Images |
|---|
      |
| Cell No. | JCRB0112.1 | Cell Name | |
|---|---|---|---|
| LOT No. | 11212005 | Lot Specification | distribution |
| Medium | RPMI1640 medium with 5% fetal bovine serum (FBS lot; GIBCO 4218333S). Use 10% FBS until cells grow well after thawing. | Temperature | 37 C |
| Cell Density at Seeding | 1 - 1.5 x 10^5 cells/ml | Methods for Passages | Dilution |
| Doubling Time | approx. 2 days | Cell Number in Vial (cells/1ml) | 1.7 x 10^6 |
| Viability at cell freezing (%) | 90.8 | Antibiotics Used | free |
| Passage Number | Unknown (6 at bank) | PDL | |
| Sterility: MYCOPLASMA | - | Sterility: BACTERIA | - |
| Sterility: FUNGI | - | Isozyme Analysis | Confirmed as human by NP, G6PD (type B), LD. |
| Chromosome Mode | Chromosome Information | ||
| Surface Antigen | DNA Profile (STR) | ||
| Adhesion | No | Exoteric Gene | |
| Medium for Freezing | 10% DMSO, 20% FBS - RPMI1640 | CO2 Conc. | 5% |
| Viability immediately after thawing (%) | Additional information |
| Cell No. | JCRB0112.1 | Cell Name | THP-1 |
|---|---|---|---|
| LOT No. | 072396 | Lot Specification | distribution |
| Medium | Temperature | ||
| Cell Density at Seeding | Methods for Passages | ||
| Doubling Time | Cell Number in Vial (cells/1ml) | ||
| Viability at cell freezing (%) | Antibiotics Used | ||
| Passage Number | PDL | ||
| Sterility: MYCOPLASMA | Sterility: BACTERIA | ||
| Sterility: FUNGI | Isozyme Analysis | G6PD, LDH, NP | |
| Chromosome Mode | Chromosome Information | ||
| Surface Antigen | DNA Profile (STR) | ||
| Adhesion | Exoteric Gene | ||
| Medium for Freezing | CO2 Conc. | ||
| Viability immediately after thawing (%) | Additional information |
| Images |
|---|
    |
| Cell No. | JCRB0112.1 | Cell Name | THP-1 |
|---|---|---|---|
| LOT No. | 012492 | Lot Specification | distribution |
| Medium | RPMI1640 medium with 10% fetal bovine serum (Cell Culture Lab.00939-01) | Temperature | 37C |
| Cell Density at Seeding | 2x10^6 cells/10cm dish | Methods for Passages | dilution |
| Doubling Time | 24 hr | Cell Number in Vial (cells/1ml) | 4.3x10^6 |
| Viability at cell freezing (%) | 95.7 | Antibiotics Used | free |
| Passage Number | P5* | PDL | NT |
| Sterility: MYCOPLASMA | - | Sterility: BACTERIA | - |
| Sterility: FUNGI | - | Isozyme Analysis | NT |
| Chromosome Mode | M=49 | Chromosome Information | NT |
| Surface Antigen | NT | DNA Profile (STR) | |
| Adhesion | No | Exoteric Gene | NT |
| Medium for Freezing | 5% DMSO | CO2 Conc. | 5% |
| Viability immediately after thawing (%) | Additional information |
| Cell No. | JCRB0112.1 | Cell Name | THP-1 |
|---|---|---|---|
| LOT No. | 112488 | Lot Specification | distribution |
| Medium | RPMI1640 + FCS 5% | Temperature | 37 |
| Cell Density at Seeding | 2-5x10^5 cells/ml | Methods for Passages | Dilution, twice a week |
| Doubling Time | NT | Cell Number in Vial (cells/1ml) | 1.6x10^6 |
| Viability at cell freezing (%) | NT | Antibiotics Used | free |
| Passage Number | P5* | PDL | |
| Sterility: MYCOPLASMA | - | Sterility: BACTERIA | - |
| Sterility: FUNGI | - | Isozyme Analysis | NP |
| Chromosome Mode | Chromosome Information | NT | |
| Surface Antigen | DNA Profile (STR) | ||
| Adhesion | Exoteric Gene | ||
| Medium for Freezing | 5% DMSO | CO2 Conc. | 5% |
| Viability immediately after thawing (%) | 89.5 | Additional information |
| Cell No. | JCRB0112.1 | Cell Name | THP-1 |
|---|---|---|---|
| LOT No. | 09222014 | Lot Specification | distribution |
| Medium | RPMI1640 medium with 5% heat-inactivated fetal bovine serum (FBS; GIBCO Cat. # 10091) use 10% FBS at the intiation of culture. | Temperature | 37 C |
| Cell Density at Seeding | 2 - 5 x 10^5 cells/mL | Methods for Passages | Simple dilution (suspension culture) |
| Doubling Time | Cell Number in Vial (cells/1ml) | 7.2 x 10^6 | |
| Viability at cell freezing (%) | 92 | Antibiotics Used | free |
| Passage Number | Unknown (10 at bank) | PDL | |
| Sterility: MYCOPLASMA | - | Sterility: BACTERIA | - |
| Sterility: FUNGI | - | Isozyme Analysis | Confirmed as human by NP, G6PD (type B), MD. |
| Chromosome Mode | Chromosome Information | ||
| Surface Antigen | DNA Profile (STR) | D5S818:11,12 D13S317:13 D7S820:10 D16S539:11,12 VWA:16 TH01:8,9.3 AM:X,Y TPOX:8,11 CSF1PO:11,13 |
|
| Adhesion | No | Exoteric Gene | |
| Medium for Freezing | Cell Banker 1 (Nippon Zenyaku Industries) | CO2 Conc. | 5% |
| Viability immediately after thawing (%) | 92 | Additional information |
| Cell No. | JCRB0112.1 | Cell Name | |
|---|---|---|---|
| LOT No. | 050297 | Lot Specification | distribution |
| Medium | RPMI1640 medium with 5% fetal calf serum (FCS lot; BioWhittaker 6M0121) | Temperature | 37 C |
| Cell Density at Seeding | 1-2 x 10^5 cells/ml | Methods for Passages | Dilution |
| Doubling Time | approx. 42 hrs | Cell Number in Vial (cells/1ml) | 1.0 x 10^6 |
| Viability at cell freezing (%) | 64.0 | Antibiotics Used | free |
| Passage Number | P7* | PDL | |
| Sterility: MYCOPLASMA | - | Sterility: BACTERIA | - |
| Sterility: FUNGI | - | Isozyme Analysis | confirmed as human by NP, G6PD (type B), MD. |
| Chromosome Mode | Chromosome Information | ||
| Surface Antigen | DNA Profile (STR) | ||
| Adhesion | No | Exoteric Gene | |
| Medium for Freezing | CO2 Conc. | ||
| Viability immediately after thawing (%) | Additional information |
| Cell No. | JCRB0112.1 | Cell Name | |
|---|---|---|---|
| LOT No. | F00952 | Lot Specification | distribution |
| Medium | RPMI1640 + 10% FCS | Temperature | 37 |
| Cell Density at Seeding | Methods for Passages | dilution | |
| Doubling Time | Cell Number in Vial (cells/1ml) | 1.6 x 10^6 | |
| Viability at cell freezing (%) | 82.0 | Antibiotics Used | free |
| Passage Number | * +5 | PDL | |
| Sterility: MYCOPLASMA | - | Sterility: BACTERIA | - |
| Sterility: FUNGI | - | Isozyme Analysis | confirmed as human by isoenzymology |
| Chromosome Mode | Chromosome Information | ||
| Surface Antigen | DNA Profile (STR) | ||
| Adhesion | No | Exoteric Gene | |
| Medium for Freezing | CO2 Conc. | ||
| Viability immediately after thawing (%) | Additional information |
| Cell No. | JCRB0112.1 | Cell Name | THP-1 |
|---|---|---|---|
| LOT No. | 10282015 | Lot Specification | distribution |
| Medium | RPMI1640 medium with 5% heat-inactivated fetal bovine serum (FBS; GIBCO Cat. # 10091). Use 10% FBS until cells grow stably. | Temperature | 37 C |
| Cell Density at Seeding | 3.0 - 7.5 x 10^5 cells/mL | Methods for Passages | Simple dilution (suspension culture). |
| Doubling Time | 66 hrs | Cell Number in Vial (cells/1ml) | 1.4 x 10^6 |
| Viability at cell freezing (%) | 86.9 | Antibiotics Used | free |
| Passage Number | Unknown (9 at bank) | PDL | |
| Sterility: MYCOPLASMA | - | Sterility: BACTERIA | - |
| Sterility: FUNGI | - | Isozyme Analysis | |
| Chromosome Mode | Chromosome Information | ||
| Surface Antigen | DNA Profile (STR) | ||
| Adhesion | No | Exoteric Gene | |
| Medium for Freezing | 10% DMSO, 20% FBS - RPMI1640 | CO2 Conc. | 5% |
| Viability immediately after thawing (%) | 86.9 | Additional information |
| Cell No. | JCRB0112.1 | Cell Name | THP-1 |
|---|---|---|---|
| LOT No. | 11012017 | Lot Specification | distribution |
| Medium | RPMI1640 medium(GIBCO) with 5% heat inactivated fetal bovine serum(SIGMA12J396) | Temperature | 37 C |
| Cell Density at Seeding | 1.19-1.21x10^5 cells/ml | Methods for Passages | dilution |
| Doubling Time | NT | Cell Number in Vial (cells/1ml) | 4.04x10^6 |
| Viability at cell freezing (%) | 100 | Antibiotics Used | free |
| Passage Number | p8* | PDL | NT |
| Sterility: MYCOPLASMA | - | Sterility: BACTERIA | - |
| Sterility: FUNGI | - | Isozyme Analysis | NT |
| Chromosome Mode | NT | Chromosome Information | NT |
| Surface Antigen | NT | DNA Profile (STR) | D5S818:11,12 D13S317:13 D7S820:10 D16S539:11,12 VWA:16 TH01:8,9.3 AM:X,Y TPOX:8,11 CSF1PO:11,13 |
| Adhesion | No | Exoteric Gene | NT |
| Medium for Freezing | RPMI1640 medium with 5% DMSO and 20%heat inactivated fetal bovine serum | CO2 Conc. | 5% |
| Viability immediately after thawing (%) | NT | Additional information | Use 10% heat inactivated fetal bovine serum until cells grow stably |
| Images |
|---|
      |
| Cell No. | JCRB0112.1 | Cell Name | THP-1 |
|---|---|---|---|
| LOT No. | 11102017 | Lot Specification | distribution |
| Medium | RPMI1640 medium(GIBCO) with 5% heat inactivated fetal bovine serum(SIGMA12J396) | Temperature | 37 C |
| Cell Density at Seeding | 1.00-1.21x10^5 cells/ml | Methods for Passages | dilution |
| Doubling Time | NT | Cell Number in Vial (cells/1ml) | 3.52x10^6 |
| Viability at cell freezing (%) | 100 | Antibiotics Used | free |
| Passage Number | p10* | PDL | NT |
| Sterility: MYCOPLASMA | - | Sterility: BACTERIA | - |
| Sterility: FUNGI | - | Isozyme Analysis | NT |
| Chromosome Mode | NT | Chromosome Information | NT |
| Surface Antigen | NT | DNA Profile (STR) | D5S818:11,12 D13S317:13 D7S820:10 D16S539:11,12 VWA:16 TH01:8,9.3 AM:X,Y TPOX:8,11 CSF1PO:11,13 |
| Adhesion | No | Exoteric Gene | NT |
| Medium for Freezing | Cell Banker BLC-1(Nihon Zenyaku Industries) | CO2 Conc. | 5% |
| Viability immediately after thawing (%) | NT | Additional information | Use 10% heat inactivated fetal bovine serum until cells grow stably. |
| Images |
|---|
      |
| Cell No. | JCRB0112.1 | Cell Name | THP-1 |
|---|---|---|---|
| LOT No. | 11092017 | Lot Specification | distribution |
| Medium | RPMI-1640 medium with 5% fetal bovine serum (FBS; Sigma Cat. # 172012). Use 10% FBS until cells stably grow. | Temperature | 37 C |
| Cell Density at Seeding | 2 - 4 x 10^5 cells/mL | Methods for Passages | Simple dilution (suspension culture). |
| Doubling Time | approx. 41 hrs. | Cell Number in Vial (cells/1ml) | 2.0 x 10^6 |
| Viability at cell freezing (%) | 98 | Antibiotics Used | free |
| Passage Number | Unknown (9 at bank) | PDL | |
| Sterility: MYCOPLASMA | - | Sterility: BACTERIA | - |
| Sterility: FUNGI | - | Isozyme Analysis | |
| Chromosome Mode | Chromosome Information | ||
| Surface Antigen | DNA Profile (STR) | ||
| Adhesion | No | Exoteric Gene | |
| Medium for Freezing | 5% DMSO, 20% FBS - RPMI1640 | CO2 Conc. | 5% |
| Viability immediately after thawing (%) | 90 | Additional information |
| Cell No. | JCRB0112.1 | Cell Name | THP-1 |
|---|---|---|---|
| LOT No. | 05242021 | Lot Specification | distribution |
| Medium | RPMI 1640 medium with 5% fetal bovine serum (FBS; Sigma Cat. # 172012). Use 10% FBS until cells grow stably. | Temperature | 37 C |
| Cell Density at Seeding | 2.5 - 4.5 x 10^5 cells/mL | Methods for Passages | Simple dilution (suspension culture). |
| Doubling Time | approx. 2 days, | Cell Number in Vial (cells/1ml) | 2.5 x 10^6 |
| Viability at cell freezing (%) | 98.5 | Antibiotics Used | free |
| Passage Number | Unknown (8 at bank) | PDL | |
| Sterility: MYCOPLASMA | - | Sterility: BACTERIA | - |
| Sterility: FUNGI | - | Isozyme Analysis | |
| Chromosome Mode | Chromosome Information | ||
| Surface Antigen | DNA Profile (STR) | ||
| Adhesion | No | Exoteric Gene | |
| Medium for Freezing | 5% DMSO, 20% FBS - RPMI1640 | CO2 Conc. | 5% |
| Viability immediately after thawing (%) | 93.6 | Additional information |
| Cell No. | JCRB0112.1 | Cell Name | THP-1 |
|---|---|---|---|
| LOT No. | 07262023 | Lot Specification | distribution |
| Medium | RPMI 1640 medium with 5% fetal bovine serum (FBS; GIBCO Cat. # 10437). Use 10% FBS until cells grow stably. | Temperature | 37 C |
| Cell Density at Seeding | 1.5 - 3.3 x 10^5 cells/mL | Methods for Passages | Simple dilution (suspension culture). |
| Doubling Time | approx. 35 hrs. | Cell Number in Vial (cells/1ml) | 3.5 x 10^6 |
| Viability at cell freezing (%) | 97 | Antibiotics Used | free |
| Passage Number | Unknown (9 at bank) | PDL | |
| Sterility: MYCOPLASMA | - | Sterility: BACTERIA | - |
| Sterility: FUNGI | - | Isozyme Analysis | |
| Chromosome Mode | Chromosome Information | ||
| Surface Antigen | DNA Profile (STR) | D5S818:11,12 D13S317:13 D7S820:10 D16S539:11,12 VWA:16 TH01:8,9.3 AM:X,Y TPOX:8,11 CSF1PO:11,13 |
|
| Adhesion | No | Exoteric Gene | |
| Medium for Freezing | 5% DMSO, 20% FBS - RPMI1640 | CO2 Conc. | 5% |
| Viability immediately after thawing (%) | 93 | Additional information |
| Cell No. | JCRB0112.1 | Cell Name | THP-1 |
|---|---|---|---|
| LOT No. | 02132024 | Lot Specification | distribution |
| Medium | RPMI 1640 medium with 5% fetal bovine serum (FBS; Nichirei Cat. # 174112, Lot 20M00K). Use 10% FBS until cells grow stably. | Temperature | 37 C |
| Cell Density at Seeding | approx. 1 x 10^5 cells/mL | Methods for Passages | Simple dilution (suspension culture). |
| Doubling Time | approx. 59 hrs. | Cell Number in Vial (cells/1ml) | 3.9 x 10^6 |
| Viability at cell freezing (%) | 96 | Antibiotics Used | free |
| Passage Number | Unknown (9 at bank) | PDL | |
| Sterility: MYCOPLASMA | - | Sterility: BACTERIA | - |
| Sterility: FUNGI | - | Isozyme Analysis | |
| Chromosome Mode | Chromosome Information | ||
| Surface Antigen | DNA Profile (STR) | D5S818:11,12 D13S317:13 D7S820:10 D16S539:11,12 VWA:16 TH01:8,9.3 AM:X,Y TPOX:8,11 CSF1PO:11,13 |
|
| Adhesion | No | Exoteric Gene | |
| Medium for Freezing | Cellbanker 1(Nippon Zenyaku Industries) | CO2 Conc. | 5% |
| Viability immediately after thawing (%) | 91 | Additional information |
| Cell No. | JCRB0112.1 | Cell Name | THP-1 |
|---|---|---|---|
| LOT No. | 11012024 | Lot Specification | distribution |
| Medium | RPMI1640 medium (GIBCO:catalog No.11875) with 5% heat inactivated fetal bovine serum (Biowest cat.No. S1820-500 LotNo.S09336S1820) | Temperature | 37 C |
| Cell Density at Seeding | 1.64-1.89x10^5cells/mL | Methods for Passages | Simple dilution |
| Doubling Time | NT | Cell Number in Vial (cells/1ml) | 3.84x10^6 |
| Viability at cell freezing (%) | 99 | Antibiotics Used | free |
| Passage Number | p8* | PDL | NT |
| Sterility: MYCOPLASMA | - | Sterility: BACTERIA | - |
| Sterility: FUNGI | - | Isozyme Analysis | NT |
| Chromosome Mode | NT | Chromosome Information | NT |
| Surface Antigen | NT | DNA Profile (STR) | D5S818:11,12 D13S317:13 D7S820:10 D16S539:11,12 VWA:16 TH01:8,9.3 AM:X,Y TPOX:8,11 CSF1PO:11,13 |
| Adhesion | No | Exoteric Gene | NT |
| Medium for Freezing | Cell Banker (Nippon Zenyaku Kogyo Co.Ltd) | CO2 Conc. | 5% |
| Viability immediately after thawing (%) | 98 | Additional information | Use 10% FBS until cells grow stably. |
| Cell No. | JCRB0112.1 | Cell Name | THP-1 |
|---|---|---|---|
| LOT No. | 11112024 | Lot Specification | distribution |
| Medium | RPMI1640 medium (GIBCO:catalog No.11875) with 5% heat inactivated fetal bovine serum (Biowest cat.No. S1820-500 LotNo.S09336S1820) | Temperature | 37 C |
| Cell Density at Seeding | 1.05-1.89x10^5 cells/mL | Methods for Passages | Simple dilution |
| Doubling Time | NT | Cell Number in Vial (cells/1ml) | 3.89x10^6 |
| Viability at cell freezing (%) | 99 | Antibiotics Used | free |
| Passage Number | p10* | PDL | NT |
| Sterility: MYCOPLASMA | - | Sterility: BACTERIA | - |
| Sterility: FUNGI | - | Isozyme Analysis | NT |
| Chromosome Mode | NT | Chromosome Information | NT |
| Surface Antigen | NT | DNA Profile (STR) | D5S818:11,12 D13S317:13 D7S820:10 D16S539:11,12 VWA:16 TH01:8,9.3 AM:X,Y TPOX:8,11 CSF1PO:11,13 |
| Adhesion | No | Exoteric Gene | NT |
| Medium for Freezing | Cell Banker (Nippon Zenyaku Kogyo Co.Ltd) | CO2 Conc. | 5% |
| Viability immediately after thawing (%) | 96 | Additional information | Use 10% FBS until cells grow stably. |
| Cell No. | JCRB0112.1 | Cell Name | THP-1 |
|---|---|---|---|
| LOT No. | 07162025 | Lot Specification | distribution |
| Medium | RPMI1640(GIBCO Cat #11875-093) with 5% heat inactivated fetal bovine serum (Nichirei Cat. # 174112, Lot 20M00K) | Temperature | 37 C |
| Cell Density at Seeding | 1.6-4.5x10^5 cells/ml | Methods for Passages | dilution |
| Doubling Time | NT | Cell Number in Vial (cells/1ml) | 2.0x10^6 |
| Viability at cell freezing (%) | 95 | Antibiotics Used | free |
| Passage Number | p9* | PDL | NT |
| Sterility: MYCOPLASMA | - | Sterility: BACTERIA | - |
| Sterility: FUNGI | - | Isozyme Analysis | NT |
| Chromosome Mode | NT | Chromosome Information | NT |
| Surface Antigen | NT | DNA Profile (STR) | D5S818:11,12 D13S317:13 D7S820:10 D16S539:11,12 VWA:16 TH01:8,9.3 AM:X,Y TPOX:8,11 CSF1PO:11,13 |
| Adhesion | No | Exoteric Gene | NT |
| Medium for Freezing | CELLBANKER1((Nihon Zenyaku Industries Cat.No.11910) | CO2 Conc. | 5% |
| Viability immediately after thawing (%) | 95 | Additional information |
| Images |
|---|
|